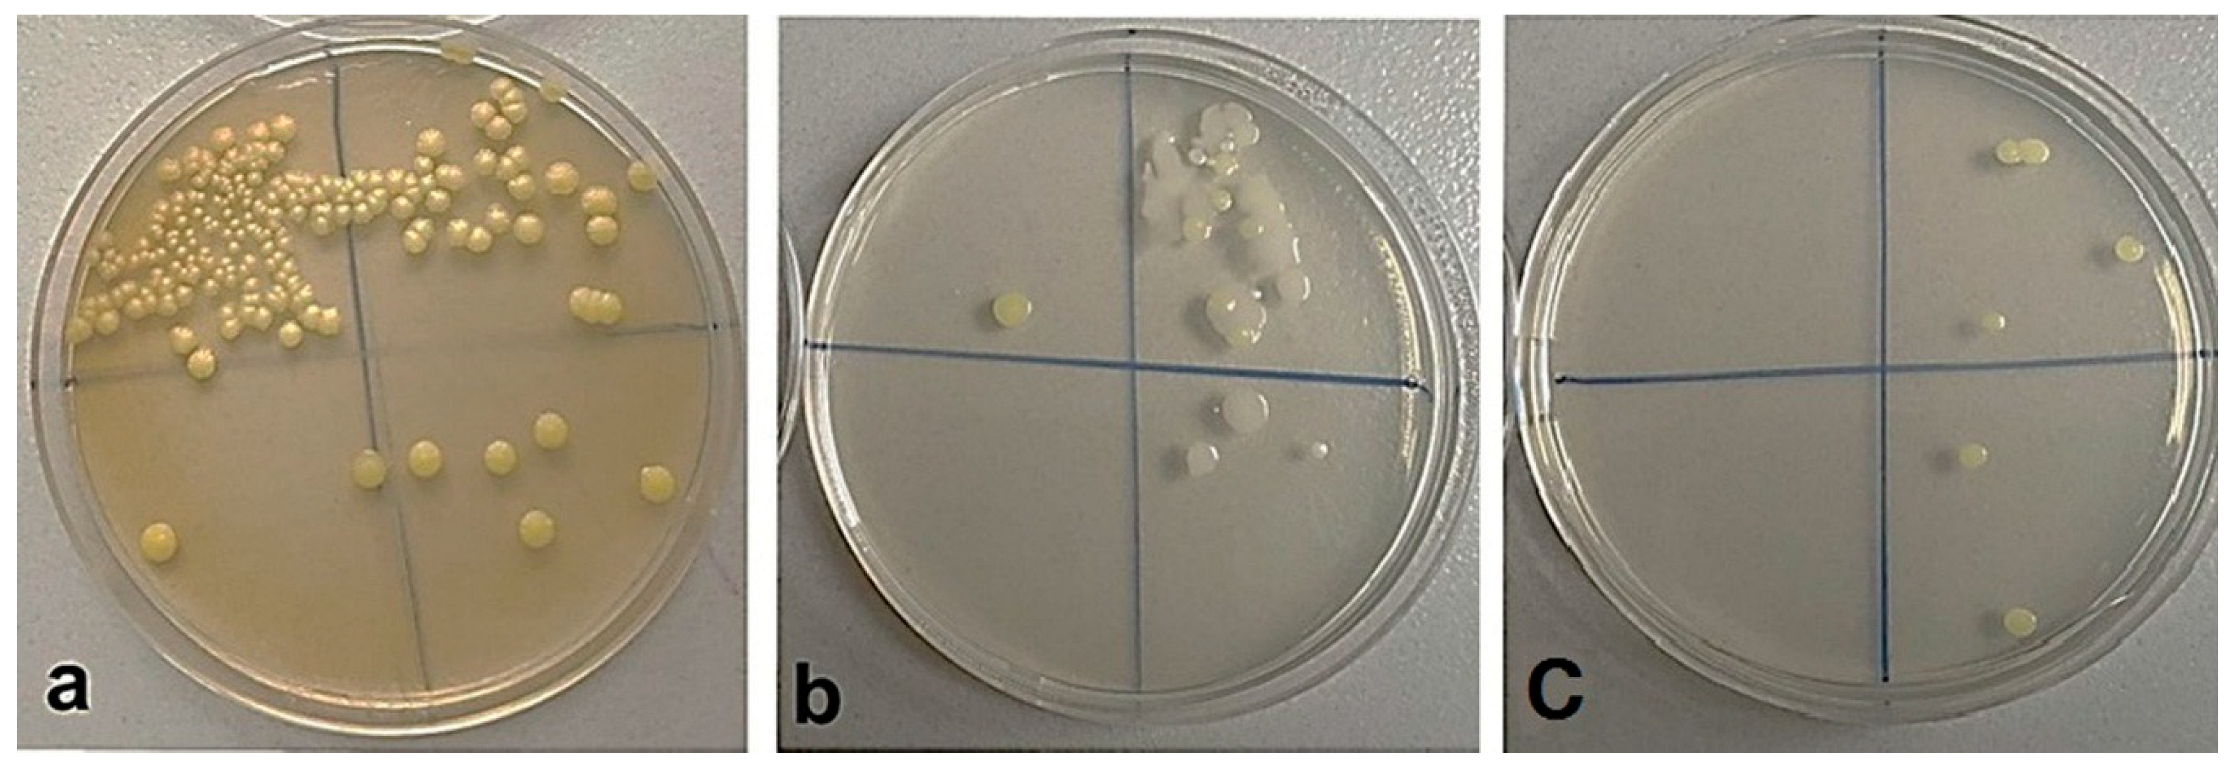

Antibacterial Amorphous–Crystalline Coatings Based on Wollastonite and ZnO Particles
Abstract
1. Introduction
2. Materials and Methods
2.1. Sample Preparation
2.2. Study of Structural, Morphological, and Mechanical Properties of Coatings
2.3. Study of Corrosion Properties of Coatings
2.4. Study of Biological Properties of Coatings
3. Results and Discussion
3.1. Structural and Morphological Properties of Coatings
3.2. Elemental and Phase Composition of Coatings
3.3. Mechanical Properties of Coatings
3.4. Corrosion Properties of Coatings
3.5. Biological Properties of Coatings
4. Conclusions
- (1)
- It has been established that a distinctive amorphous–crystalline structure was formed in the obtained coatings, consisting of zinc oxide and wollastonite particles on the surface and zinc oxide particles in the coating volume. Due to the difference in melting temperatures, zinc oxide ZnO (Tm = 1975 °C) was retained in the coating during the MAO process, while wollastonite (Tm = 1544 °C) melted in the channels of micro-arc discharges, but it was deposited on the coating surface at the final stage of the process.
- (2)
- Increasing the voltage from 350 to 500 V resulted in an overall increase in the coating thickness from 25 to 124 μm, while the proportion of Zn in the coating also increased from 2.6 to 8.6 at.%.
- (3)
- The following crystalline phases were found in the coatings: wollastonite (CaSiO3), forsterite (Mg2SiO4), magnesium oxide MgO (periclase), and zinc oxide ZnO. When the voltage of the MAO process was increased from 350 to 500 V, the proportion of amorphous phase in the coatings increased from 31 to 68 vol%.
- (4)
- The coating formed at 350 V was characterized by the highest mechanical strength, since the values of critical load and microhardness were maximum, equal to 16.6 N and 411 HV, respectively. This is explained by the fact that this coating had a uniform porous structure, minimum roughness equal to 2.5 µm, and the highest crystallinity.
- (5)
- The 500 V coating had the highest corrosion resistance since it was characterized by the lowest value of corrosion current density, equal to 1.60 × 10−9 A·cm−2, and the highest value of polarization resistance, equal to 3.86 × 107 Ω·cm2.
- (6)
- In addition, the coating synthesized at 500 V was characterized by the highest antibacterial activity against S. aureus (Z = 99.1%) but also by the ability to intensify the proliferative activity of NIH/3T3 cells, since after 48 h of cultivation with the coating extract, the number of viable cells increased to 104.9% compared to the control.
- (7)
- By varying the voltage of the MAO process, it is possible to alter the structural, morphological, mechanical, corrosion and biological properties of the resulting coatings.
Author Contributions
Funding
Data Availability Statement
Acknowledgments
Conflicts of Interest
References
- Li, Y.; Jahr, H.; Zhou, J.; Zadpoor, A.A. Additively manufactured biodegradable porous metals. Acta Biomater. 2020, 115, 29–50. [Google Scholar] [CrossRef] [PubMed]
- Heimann, R.B. Magnesium alloys for biomedical application: Advanced corrosion control through surface coating. Surf. Coat. Technol. 2021, 405, 126521. [Google Scholar] [CrossRef]
- Heiden, M.; Walker, E.; Stanciu, L. Magnesium, iron and zinc alloys the trifecta of bioresorbable orthopaedic and vascular implantation—A Review. J. Biotechnol. Biomater. 2015, 5, 1000178. [Google Scholar] [CrossRef]
- Esmaily, M.; Svensson, J.E.; Fajardo, S.; Birbilis, N.; Frankel, G.S.; Virtanen, S.; Arrabal, R.; Thomas, S.; Johansson, L.G. Fundamentals and advances in magnesium alloy corrosion. Prog. Mater. Sci. 2017, 89, 92–193. [Google Scholar] [CrossRef]
- Tsakiris, V.; Tardei, C.; Clicinschi, F.M. Biodegradable Mg alloys for orthopedic implants –A review. J. Magnes. Alloys 2021, 9, 1884–1905. [Google Scholar] [CrossRef]
- Tong, P.; Sheng, Y.; Hou, R.; Iqbal, M.; Chen, L.; Li, J. Recent progress on coatings of biomedical magnesium alloy. Smart Mater. Med. 2022, 3, 104–116. [Google Scholar] [CrossRef]
- Putra, N.E.; Mirzaali, M.J.; Apachitei, I.; Zhou, J.; Zadpoor, A.A. Multi-material additive manufacturing technologies for Ti-, Mg-, and Fe-based biomaterials for bone substitution. Acta Biomater. 2020, 109, 1–20. [Google Scholar] [CrossRef]
- Raman, R.K.; Harandi, S.E. Resistance of magnesium alloys to corrosion fatigue for biodegradable implant applications: Current status and challenges. Materials 2017, 10, 1316. [Google Scholar] [CrossRef]
- Li, Z.; Gu, X.; Lou, S.; Zheng, Y. The development of binary Mg-Ca alloys for use as biodegradable materials within bone. Biomaterials 2008, 29, 1329–1344. [Google Scholar] [CrossRef]
- Zhang, S.; Li, J.; Song, Y.; Zhao, C.; Zhang, X.; Xie, C.; Zhang, Y.; Tao, H.; He, Y.; Jiang, Y.; et al. In vitro degradation, hemolysis and MC3T3-E1 cell adhesion of biodegradable Mg-Zn alloy. Mater. Sci. Eng. C 2009, 29, 1907–1912. [Google Scholar] [CrossRef]
- Vinogradov, A.; Vasilev, E.; Kopylov, V.I.; Linderov, M.; Brilevesky, A.; Merson, D. High performance fine-grained biodegradable Mg-Zn-Ca alloys processed by severe plastic deformation. Metals 2019, 9, 186. [Google Scholar] [CrossRef]
- Guo, X.; Hu, Y.; Yuan, K.; Qiao, Y. Review of the effect of surface coating modification on magnesium alloy biocompatibility. Materials 2022, 15, 3291. [Google Scholar] [CrossRef] [PubMed]
- Saha, S.; Lestari, W.; Dini, C.; Sarian, M.N.; Hermawan, H.; Barão, V.A.R.; Sukotjo, C.; Takoudis, C. Corrosion in Mg-alloy biomedical implants-the strategies to reduce the impact of the corrosion inflammatory reaction and microbial activity. J. Magnes. Alloy. 2022, 10, 3306–3326. [Google Scholar] [CrossRef]
- Razavi, M.; Fathi, M.; Savabi, O.; Beni, B.H.; Vashaee, D.; Tayebi, L. Surface microstructure and in vitro analysis of nanostructured akermanite (Ca2MgSi2O7) coating on biodegradable magnesium alloy for biomedical applications. Colloids Surf. B Biointerfaces 2014, 117, 432–440. [Google Scholar] [CrossRef] [PubMed]
- Sayed, M.; Mahmoud, E.M.; Bondioli, F.; Naga, S.M. Developing porous diopside/hydroxyapatite bio-composite scaffolds via a combination of freeze-drying and coating process. Ceram. Int. 2019, 45, 9025–9031. [Google Scholar] [CrossRef]
- Palakurthy, S.; Reddy, K.V.G.; Samudrala, R.K.; Azeem, P.A. In vitro bioactivity and degradation behaviour of β-wollastonite derived from natural waste. Mat. Sci. Eng. C. 2019, 98, 109–117. [Google Scholar] [CrossRef]
- Kashin, A.D.; Sedelnikova, M.B.; Chebodaeva, V.V.; Uvarkin, P.V.; Luginin, N.A.; Dvilis, E.S.; Kazmina, O.V.; Sharkeev, Y.P.; Khlusov, I.A.; Miller, A.A.; et al. Diatomite-based ceramic biocoating for magnesium implants. Ceram. Int. 2022, 48, 28059–28071. [Google Scholar] [CrossRef]
- Sedelnikova, M.B.; Ugodchikova, A.V.; Tolkacheva, T.V.; Chebodaeva, V.V.; Cluklhov, I.A.; Khimich, M.A.; Bakina, O.V.; Lerner, M.I.; Egorkin, V.S.; Schmidt, J.; et al. Surface modification of Mg0.8Ca alloy via wollastonite micro-arc coatings: Significant improvement in corrosion resistance. Metals 2021, 11, 754. [Google Scholar] [CrossRef]
- Sedelnikova, M.; Bakina, O.; Ugodchikova, A.; Tolkacheva, T.; Khimich, M.; Uvarkin, P.; Kashin, A.; Miller, A.; Egorkin, V.; Schmidt, J.; et al. The Role of Microparticles of β-TCP and Wollastonite in the Creation of Biocoatings on Mg0.8Ca Alloy. Metals 2022, 12, 1647. [Google Scholar] [CrossRef]
- Rudnev, V.S.; Yarovaya, T.P.; Gaivarotskaya, K.A.; Nedozorov, P.M.; Kaidalova, T.A.; Didenko, N.A.; Gerasimenko, A.V. MOx–ZrO2 Coatings with M=Al, Mg, Zr, Ti, and Nb on Valve Metals. Prot. Met. Phys. Chem. Surf. 2010, 46, 640–644. [Google Scholar] [CrossRef]
- Molaei, M.; Fattah-alhosseini, A.; Nouri, M.; Nourian, A. Systematic optimization of corrosion, bioactivity, and biocompat-ibility behaviors of calcium-phosphate plasma electrolytic oxidation (PEO) coatings on titanium substrates. Ceram. Int. 2022, 48, 6322–6337. [Google Scholar] [CrossRef]
- Wang, H.; Xiong, C.; Yu, Z.; Zhang, J.; Huang, Y.; Zhou, X. Research progress on antibacterial coatings for preventing implant-related infection in fractures: A literature review. Coatings 2022, 12, 1921. [Google Scholar] [CrossRef]
- Oleshko, O.; Husak, Y.; Korniienko, V.; Pshenychnyi, R.; Varava, Y.; Kalinkevich, O.; Pisarek, M.; Grundsteins, K.; Pogorielova, O.; Mishchenko, O.; et al. Biocompatibility and antibacterial properties of ZnO-incorporated anodic oxide coatings on TiZrNb alloy. Nanomaterials 2020, 10, 2401. [Google Scholar] [CrossRef] [PubMed]
- Chebodaeva, V.V.; Sedelnikova, M.B.; Bakina, O.V.; Sinebrukhov, S.L.; Egorkin, V.S.; Sharkeev, Y.P. Corrosion behavior of CaP coatings formed by micro-arc oxidation and modified by metal based nanoparticles. AIP Conf. Proc. 2022, 2509, 020038. [Google Scholar] [CrossRef]
- Truc, V.D.; Nguyen, T.V.; Vu, T.V.; Nguyen, T.A.; Ngo, T.D.; Le, T.T.; Le, T.L.; Pham, L.T.; Tran, L.D. ZnO–Ag hybrid nanoparticles used in the antimicrobial solvent-based coatings: Antibacterial studies in the darkness and under visible-light irradiation. ChemistrySelect 2023, 8, e202204966. [Google Scholar] [CrossRef]
- Puspasari, V.; Ridhova, A.; Hermawan, A.; Amal, M.I.; Khan, M.M. ZnO-based antimicrobial coatings for biomedical applications. Bioprocess Biosyst. Eng. 2022, 45, 1421–1445. [Google Scholar] [CrossRef]
- Vibornijs, V.; Zubkins, M.; Strods, E.; Rudevica, Z.; Korotkaja, K.; Ogurcovs, A.; Kundzins, K.; Purans, J.; Zajakina, A. Analysis of antibacterial and antiviral properties of ZnO and Cu coatings deposited by magnetron sputtering: Evaluation of cell viability and ROS production. Coatings 2024, 14, 14. [Google Scholar] [CrossRef]
- Fathyunes, L.; Hosseini, M.; Khalil-Allafi, J. In-vitro biocompatibility, antibacterial activity, and corrosion resistance of HA-TiO2/ZnO coating fabricated by plasma electrolytic oxidation on Ti6Al4V. Mater. Today Communicat. 2024, 40, 109443. [Google Scholar] [CrossRef]
- Shen, Y.; Shan, X.; Etim, I.P.; Siddiqui, M.A.; Yang, Y.; Shi, Z.; Su, X.; Chen, J. Comparative study of the effects of nano ZnO and CuO on the biodegradation, biocompatibility, and antibacterial properties of micro-arc oxidation coating of magnesium alloy. Acta Metall. Sin. (Engl. Lett.) 2024, 37, 242–254. [Google Scholar] [CrossRef]
- Liu, D.; Deng, J.; Liu, Z.; Jin, J.; Bi, Y.; Yang, J.; Zhou, S. Effects of ZnO nanoparticles addition to plasma electrolytic oxidation coatings on magnesium alloy: Microstructure, in vitro corrosion and antibacterial properties. J. Mater. Res. 2022, 37, 2897–2909. [Google Scholar] [CrossRef]
- Elsayed, F.R.; Hort, N.; Salgado-Ordorica, M.A.; Kainer, K.U. Magnesium permanent mold castings optimization. Mater. Sci. Forum 2011, 690, 65–68. [Google Scholar] [CrossRef]
- Sedelnikova, M.B.; Komarova, E.G.; Sharkeev, Y.P.; Ugodchikova, A.V.; Tolkacheva, T.V.; Rau, J.V.; Buyko, E.E.; Ivanov, V.V.; Sheikin, V.V. Modification of titanium surface via Ag-, Sr- and Si-containing micro-arc calcium phosphate coating. Bioact. Mater. 2019, 4, 224–235. [Google Scholar] [CrossRef] [PubMed]
- Nahum, E.Z.; Lugovskoy, S.; Lugovskoy, A.; Kazanski, B.; Sobolev, A. The study of hydroxyapatite growth kinetics on CP—Ti and Ti65Zr treated by Plasma electrolytic oxidation process. J. Mater. Res. Technol. 2023, 24, 2169–2186. [Google Scholar] [CrossRef]
- Kaseem, M.; Fatimah, S.; Nashrah, N.; Ko, Y.G. Recent progress in surface modification of metals coated by plasma electrolytic oxidation: Principle, structure, and performance. Prog. Mater. Sci. 2021, 117, 100735. [Google Scholar] [CrossRef]
- Darband, G.B.; Aliofkhazraei, M.; Hamghalam, P.; Valizade, N. Plasma electrolytic oxidation of magnesium and its alloys: Mechanism, properties and applications. J. Magnes. Alloys 2017, 5, 74–132. [Google Scholar] [CrossRef]
- Clyne, T.W.; Troughton, S.C. A review of recent work on discharge characteristics during plasma electrolytic oxidation of various metals. Intern. Mater. Rev. 2019, 64, 127–162. [Google Scholar] [CrossRef]
- Troughton, S.C.; Nominé, A.; Dean, J.; Clyne, T.W. Effect of individual discharge cascades on the microstructure ofplasma electrolytic oxidation coatings. Appl. Surf. Sci. 2016, 389, 260–269. [Google Scholar] [CrossRef]
- Fattah-alhosseini, A.; Chaharmahali, R.; Babaei, K. Effect of particles addition to solution of plasma electrolytic oxidation (PEO) on the properties of PEO coatings formed on magnesium and its alloys: A review. J. Magnes. Alloys 2020, 8, 799–818. [Google Scholar] [CrossRef]
- Randall, N.X. The current state-of-the-art in scratch testing of coated systems. Surf. Coat. Technol. 2019, 380, 125092. [Google Scholar] [CrossRef]

| Element | Element Content, at.% | |||
|---|---|---|---|---|
| 350 V | 400 V | 450 V | 500 V | |
| O Kα | 59.3 ± 0.1 | 56.6 ± 0.6 | 58.2 ± 0.2 | 56.2 ± 1.8 |
| Na Kα | 2.7 ± 0.2 | 4.8 ± 0.3 | 5.9 ± 0.2 | 6.2 ± 0.4 |
| Mg Kα | 18.1 ± 1.2 | 9.0 ± 2.1 | 8.1 ± 1.3 | 8.4 ± 1.6 |
| Si Kα | 13.2 ± 0.2 | 13.8 ± 0.5 | 14.4 ± 0.2 | 14.0 ± 0.4 |
| Ca Kα | 4.1 ± 0.5 | 7.8 ± 1.3 | 7.0 ± 1.1 | 6.7 ± 1.0 |
| Zn Kα | 2.6 ± 0.3 | 7.9 ± 1.3 | 6.5 ± 1.4 | 8.6 ± 1.8 |
| Element | Element Content, at.% | |||
|---|---|---|---|---|
| 350 V | 400 V | 450 V | 500 V | |
| O Kα | 53.6 ± 1.3 | 55.1 ± 1.7 | 53.3 ± 0.9 | 54.3 ± 1.5 |
| Na Kα | 1.0 ± 0.2 | 3.2 ± 0.8 | 6.0 ± 0.5 | 2.7 ± 0.3 |
| Mg Kα | 33.5 ± 0.9 | 25.5 ± 1.3 | 21.0 ± 0.8 | 26.3 ± 0.7 |
| Si Kα | 8.9 ± 0.3 | 10.0 ± 0.6 | 10.3 ± 0.6 | 10.3 ± 0.4 |
| Ca Kα | 1.3 ± 0.2 | 1.6 ± 0.2 | 1.7 ± 0.3 | 1.8 ± 0.2 |
| Zn Kα | 1.7 ± 0.1 | 4.5 ± 0.4 | 7.7 ± 0.4 | 4.6 ± 0.5 |
| Applied Voltage, V | Eocp, V | Ecorr, V | jcorr, A·cm−2 | Rp, Ω·cm2 |
|---|---|---|---|---|
| Mg alloy | –1.51 | –1.48 | 2.08 × 10−5 | 2.40 × 103 |
| 350 | –1.41 | –1.39 | 1.91 × 10−7 | 2.82 × 105 |
| 400 | –1.43 | –1.42 | 3.30 × 10−7 | 2.20 × 105 |
| 450 | –0.28 | –0.30 | 7.29 × 10−8 | 8.18 × 105 |
| 500 | –0.50 | –0.53 | 1.60 × 10−9 | 3.86 × 107 |
| Applied Voltage, V | Antibacterial Activity | |
|---|---|---|
| CFU/ml | Z, % | |
| 350 V | (2.35 ± 0.04) × 104 | 90.5 |
| 500 V | (2.15 ± 0.04) × 103 | 99.1 |
Disclaimer/Publisher’s Note: The statements, opinions and data contained in all publications are solely those of the individual author(s) and contributor(s) and not of MDPI and/or the editor(s). MDPI and/or the editor(s) disclaim responsibility for any injury to people or property resulting from any ideas, methods, instructions or products referred to in the content. |
© 2024 by the authors. Licensee MDPI, Basel, Switzerland. This article is an open access article distributed under the terms and conditions of the Creative Commons Attribution (CC BY) license (https://creativecommons.org/licenses/by/4.0/).
Share and Cite
Sedelnikova, M.B.; Mayer, V.V.; Bakina, O.V.; Kashin, A.D.; Uvarkin, P.V.; Khimich, M.A.; Luginin, N.A.; Glukhov, I.A.; Tolkacheva, T.V.; Ugodchikova, A.V.; et al. Antibacterial Amorphous–Crystalline Coatings Based on Wollastonite and ZnO Particles. Crystals 2024, 14, 886. https://doi.org/10.3390/cryst14100886
Sedelnikova MB, Mayer VV, Bakina OV, Kashin AD, Uvarkin PV, Khimich MA, Luginin NA, Glukhov IA, Tolkacheva TV, Ugodchikova AV, et al. Antibacterial Amorphous–Crystalline Coatings Based on Wollastonite and ZnO Particles. Crystals. 2024; 14(10):886. https://doi.org/10.3390/cryst14100886
Chicago/Turabian StyleSedelnikova, Mariya B., Violetta V. Mayer, Olga V. Bakina, Alexander D. Kashin, Pavel V. Uvarkin, Margarita A. Khimich, Nikita A. Luginin, Ivan A. Glukhov, Tatiana V. Tolkacheva, Anna V. Ugodchikova, and et al. 2024. "Antibacterial Amorphous–Crystalline Coatings Based on Wollastonite and ZnO Particles" Crystals 14, no. 10: 886. https://doi.org/10.3390/cryst14100886
APA StyleSedelnikova, M. B., Mayer, V. V., Bakina, O. V., Kashin, A. D., Uvarkin, P. V., Khimich, M. A., Luginin, N. A., Glukhov, I. A., Tolkacheva, T. V., Ugodchikova, A. V., & Sharkeev, Y. P. (2024). Antibacterial Amorphous–Crystalline Coatings Based on Wollastonite and ZnO Particles. Crystals, 14(10), 886. https://doi.org/10.3390/cryst14100886

